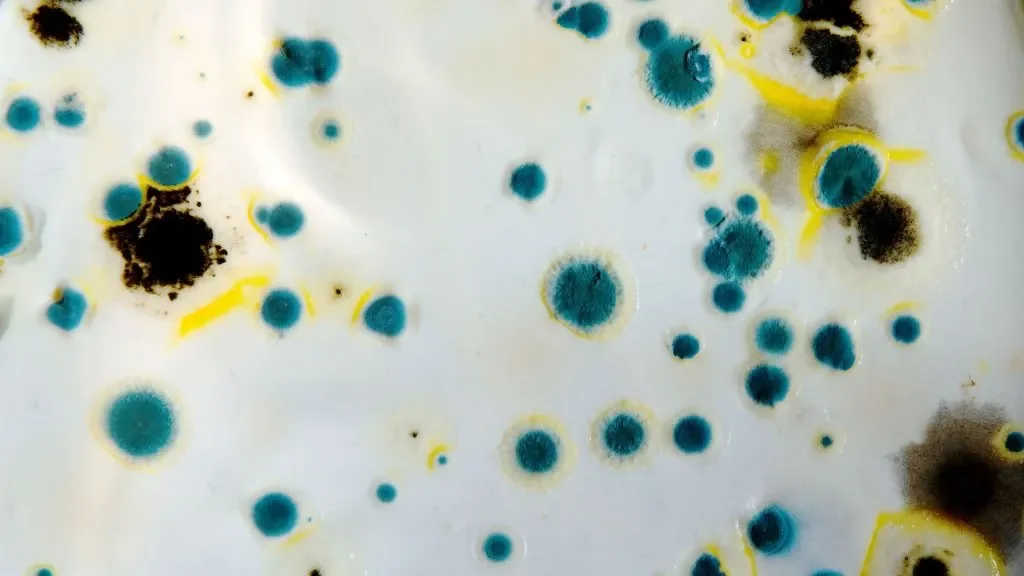

10 Warning Signs of Mold Toxicity
Did you know that exposure to mold could be affecting your health? If there is mold growing undetected in your home or workplace, it could be making you sick. Toxic mold symptoms range from allergic reactions and congestion to headaches, fatigue, confusion, and even depression. However, because they vary so widely, the symptoms of mold exposure often get mistaken for other illnesses. Let’s explore the 10 warning signs of mold toxicity and what to do about them.
If mold is making you sick, the best course of action is to get it removed right away. The mold remediation professionals at My Pure Environment can help you determine whether there is toxic mold in your home, and help you get rid of it for good. Here’s how to recognize the signs of mold sickness, so that you know when to call in the experts.
What Causes Mold Sickness?
Spores from toxigenic molds can have serious health effects on people who are sensitive to them. Most people are not affected by mold, because their immune systems produce antibodies that combat its biotoxins. However, about 25% of people lack the genetic ability to make those antibodies and can fall victim to mold allergies, mold sickness, and mold toxicity.
Toxic Mold Symptoms
Mold sickness often affects multiple systems in your body at the same time. It could impact your respiratory system, nervous system, digestive system, and even your mental health. Since it is a multi-symptom disease, it can be difficult to diagnose. Mold toxicity affects everyone differently, so the combination of symptoms will also vary from person to person.
10 Warning Signs of Mold Toxicity
Irritated Eyes or Light Sensitivity
Coughing and Congestion
Shortness of Breath
Fatigue or Weakness
Numbness or Tingling
Excessive Thirst and Frequent Urination
Headaches and Body Aches
Brain Fog or Memory Loss
Mood Swings and Confusion
Anxiety and Depression
If you’re experiencing multiple symptoms from the list above, there’s a chance that you are suffering from toxic mold exposure. Mold can grow anywhere that it finds enough humidity, and it prefers the dark. It often grows in places where you can’t see it, like behind the walls or inside your attic insulation. If your home has a musty smell or has had any recent water damage, you should definitely call for a mold inspection.
Schedule a Mold Inspection Today
For toxic mold testing and remediation services, call on the experts at My Pure Environment SF. We’ll start with an initial inspection to determine the extent of the mold in your home. If we find any signs of toxic mold, we will recommend our complete inspection, which includes 2 air samples. We’ll give you a copy of the test results that show exactly what kind of mold you’re dealing with so you can talk to your doctor about how it might be affecting your health.
We offer mold inspections and mold testing in San Francisco Bay Area. Our mold removal services are fast-acting and demolition-free, and they come with a 12-month guarantee. No matter what type of mold you have, the sooner you get it removed, the sooner your health will improve! Start breathing easier today.
Photo by Uday Mittal on Unsplash used with permission under the Creative Commons license for commercial use 12/11/2021.